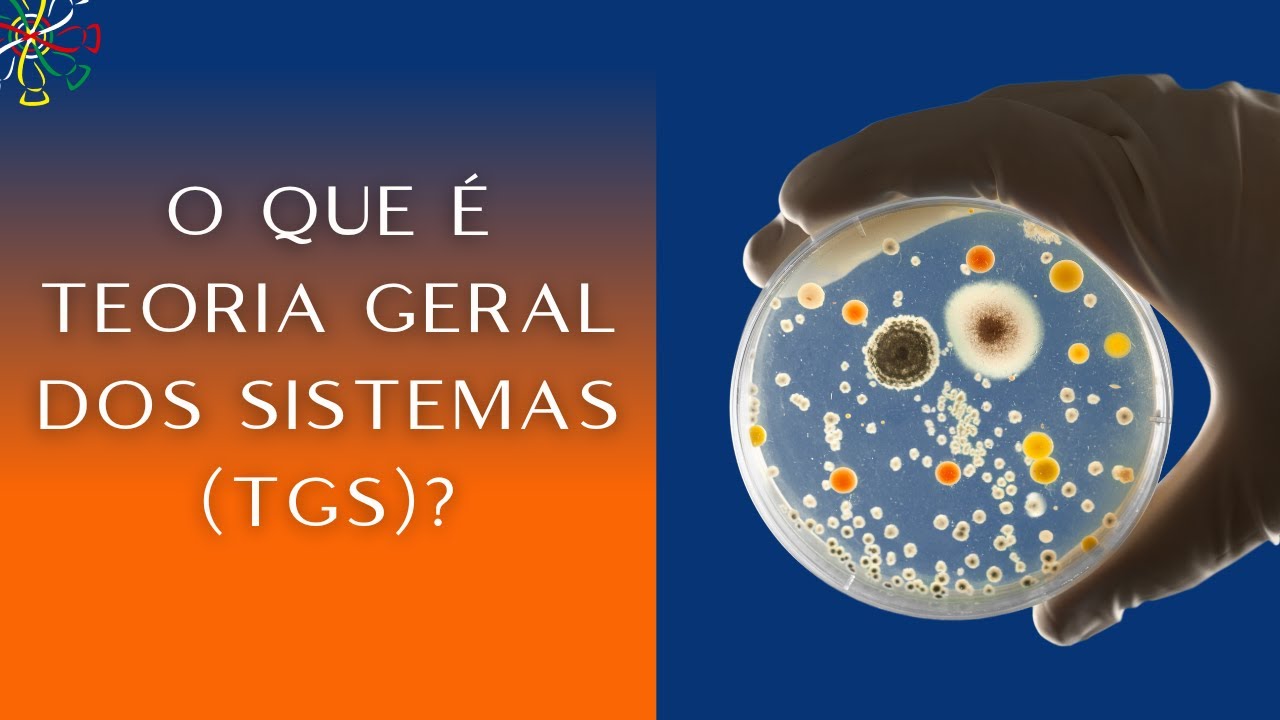
O que é a Teoria Geral dos Sistemas?

Atomic system, cellular system, digestive system, information system, Unified Health System. All of these are somehow interconnected. Are you interested in the subject?
Click like, subscribe and consider supporting our work through Pix. I'll leave my key in the description and come with me. [Music] General Systems Theory was a book published by the Austrian biologist Ludwig von Bertalanffy, in 1968.
However, this date is not the launch of systems theory studies . These studies began years ago and Bertalanffy himself was one of the pioneers. What happened is that since the beginning of system theory studies in the 1920s there has been a boom in debates and theses on the subject.
Some very well-known names associated with Systems Theory are John von Neumann and Alan Turing. The subject is so vast that if you search for General Systems Theory you will find several works. So, with his book, Bertalanffy tries to clarify his ideas and views on this topic that was being discussed so much.
Bertalanffy began his academic studies in the 1920s in the field of biology. In these studies, when thinking about the association between parts of biology, such as a system of an organism that keeps it alive, the circulatory system made up of the heart, veins, arteries and blood or the respiratory system made up of the nose, larynx, lungs, bronchi, The question came: would these relationships go further? The answer he got was yes and from there his academic works on Systems Theory were born, which would quickly be followed by several others.
Systems Theory thinks that the elements in the most diverse areas of knowledge are related to each other, constituting interconnected groups. This form of vision is a contrast to the atomistic model and the Cartesian model, which considered each area of science isolated and thought that the greater the division of an object of research into smaller parts, the better the understanding. The doctor specializes only in ophthalmology, the mechanic who only knows the electrical part of the car.
a historian who only knows the era of great navigation are cases of atomism. It is the isolated view of a field of science with emphasis on one part and without considering the correlation with others. Let's consider a hypothetical example of how Systems Theory sees the functioning of science.
Imagine that there is a large piece of land without an owner and that homeless people begin to settle in this area without any planning, building houses with pieces of wood and zinc. With the construction in disarray, there were no water and sewage network installations. People then drink well water and use septic tanks for their biological needs.
The sewage from the septic tank comes into contact with the water people drink and they begin to contract schistosomiasis. In this framework we can look at three sciences: social sciences study the issue of poverty and the occupation of vacant areas to build a house; architecture and urbanism study how the area was occupied and how it happened without the construction of a water and sewage network; Health sciences will deal with the treatment of people with schistosomiasis. In this way, we place the situation in the atomistic model, in which each area of knowledge will take care of its own field.
Now let's broaden our perspective. Let's start with the healthcare area. Professionals will assist patients to help them improve and prescribe treatment.
The treatment may work, but it does not resolve the cause of contamination, which is social conditions and poor housing conditions. If someone in the health sector wants to have real knowledge of this problem, they will have to consider what is posed by social sciences and architecture and urbanism. From the perspective of architecture and urbanism, when analyzing how residences were built without water and sewage networks, scholars in this area must consider that this was the result of a social problem, poverty, and also need to keep in mind that the absence These services resulted in the proliferation of schistosomiasis.
The work in this area would never be complete without considering social and health issues. In turn, social sciences, when analyzing the living conditions caused by poverty in this place, must consider that people do not have water and sewage and this causes health problems. Without this, they would have an incomplete analysis of reality.
So, all these areas, in order to actually be able to clearly observe a given problem, cannot close in on themselves. They need to observe relationships with other areas. This word is fundamental to understanding Systems Theory: relationship.
A system is a certain element that is composed of several parts among themselves. The human body is a system where all organs work to keep you alive. Astronomy is a system, as the different celestial bodies function as a system.
Or in atomic physics, where protons and electrons interact for an atom to exist. These examples of natural systems are the most obvious, but many of them are born from human actions. One case is information systems.
Imagine a company with 12 sectors. For every three sectors there is a local server and the local servers connect to a central server. This is a clear case of a man-made system.
Bertalanffy himself mentions several times how Systems Theory is fundamental to cybernetics. Another case of system is traffic. If some street junctions have traffic lights, the flow of traffic depends on their operation.
If two lights at the same junction turn green there is a high risk of an accident. Hence we have more information about Systems Theory: relationships must occur without errors so as not to harm the entire system. If one information channel fails in a company's information system, the whole will be harmed.
If the sales department is unable to enter the day's sales into the system, they will not be computed and the company will not be able to deliver the products, resulting in financial problems and customer complaints. And if the heart in someone's body stops working, everything else will also stop and the person dies. As we have already stated, cybernetics was one of the areas most influenced by systems theory.
Whether it is a program, in relation to software and hardware or in computing networks, everything follows the system's perspective. The text browser is an example. When you click save the document, the command triggers the save function because the code was created for that.
If you click save and it deletes your document, a system error has occurred. Another area greatly influenced by Systems Theory was administration. The operating model of a factory follows this format.
Let's take a metal products factory. The first sector is supply management or warehouse storage. This sector stores metal sheets and sends them to production.
In production, it goes through the cutting sector, then machining, welding, painting and goes to shipping, where the final product will be sent to the customer. A clear case of a system where all parts are interdependent for everything to work. One point that the author emphasizes is in relation to open and closed systems.
Open systems are those that relate to other areas of knowledge and that tend to change or seek evolution or improvement. The aforementioned case of the disorderly occupied area characterizes an open system. If the social areas, architecture and urbanism and health interact with each other and produce a change, the installation of the sewage network, we have an open system.
The information networks of a company or its production line are closed systems. They do not interact with other fields, being closed within themselves and are not usually prone to changes. This formulation of System Theory still made Bertalanffy consider some problems that could occur.
The first of these would be the hierarchy with the primacy of physics over other scientific currents. This problem can arise because every object of study can ultimately be reduced to atoms. We have a society, society is made up of individuals, individuals are made up of organs, organs are made up of tissues, tissues are made up of cells and cells are made up of atoms.
Thus, physics could be considered a science behind all the others, while the true purpose of Systems Theory is to think about a horizontal relationship between them without any one being on top of the other. Another problem he highlighted was the risk of human beings being mechanized in closed systems mainly in companies. Human beings are by nature open systems.
They relate to the planet, to ecosystems, to other humans, to various systems created by humanity. Being regularly trapped in a company's closed system could eliminate this foundation of humanity. The risk of totalitarianism and dictatorship is associated with the previous problem.
A human society thought of as a system could be a justification for tyrants wanting to control people in a closed system. Regimes like the Nazis proved that this is possible, creating a system of mass elimination of human beings. With this, we were able to gain insight into how Bertalanffy conceives Systems Theory.
He does so by placing his own perspectives on a line of thought with several relevant authors producing and he does so by placing a strong emphasis on human participation in this issue.